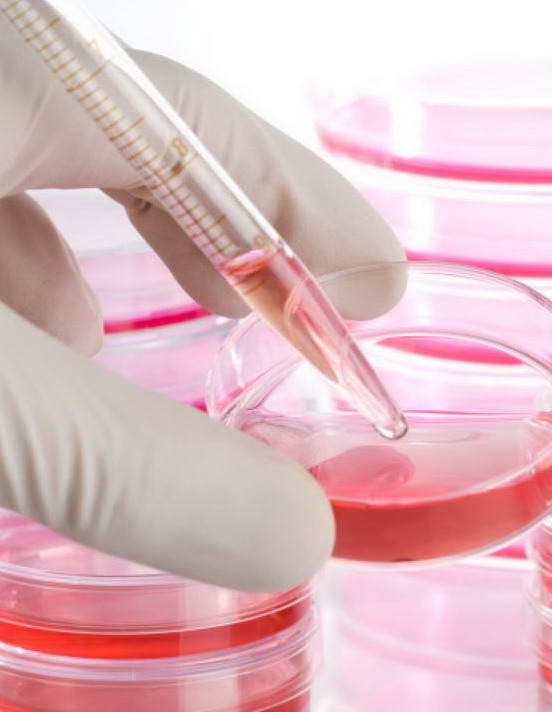
Research

Il Tar del Lazio, mercoledì 4 dicembre, ha sospeso il decreto di nomina del Comitato scientifico, chiamato dal Ministero a pronunciarsi sul metodo Stamina (cura a base di cellule staminali), e il parere contrario alla sperimentazione che lo stesso Comitato aveva espresso. Nel mondo scientifico non è stata accolta bene la scelta del Tar. A Bruno Dallapiccola, genetista, direttore scientifico dell’Ospedale pediatrico Bambino Gesù e membro del Comitato, abbiamo chiesto di commentare questa decisione.
Professore, cosa ne pensa?
«Siamo stati retrocessi in serie B solo perché il Tar ritiene che all’interno del gruppo di lavoro ci fossero persone di parte. A me fa molto piacere che ora si vada verso una Commissione internazionale, la quale non potrà che ribadire quanto è stato fatto dal nostro Comitato. Mi dispiace che il lavoro capillare da noi compiuto non sia stato fatto conoscere agli esperti e siano rimasti margini di dubbio. In realtà, tutti parlano di questo metodo Stamina, ma solo pochi l’hanno potuto vedere: il nostro gruppo e, prima di noi, il Comitato che approva i brevetti negli Stati Uniti, che lo ha bocciato. Certo, se dopo le verifiche dell’Aifa e i pareri del gruppo di esperti, di un premio Nobel come Yamanaka, della comunità scientifica internazionale, c’è ancora bisogno di un’ennesima verifica, non arriveremo mai alla fine di questa vicenda».
Come risponde alla decisione del Tar?
«Lascia dei dubbi il fatto che abbia espresso dei giudizi senza guardare molto bene le carte. Il Tar dice che il Comitato avrebbe dovuto andare a vedere i pazienti, ma non è così. Il decreto di nomina del Comitato prevedeva una valutazione del protocollo e un’individuazione delle malattie eventualmente da sottoporre a sperimentazione. Non c’era scritto che bisognava andare a vedere i risultati sui pazienti. Ma se pure fosse stato previsto, sarebbe stato inutile: per verificare se una terapia è efficace si deve far partire la sperimentazione secondo i protocolli della buona pratica clinica. Ma a Brescia non è stato così. D’altra parte, come mai, pur essendo una terapia attuata da anni in giro per l’Italia, non abbiamo avuto testimonianze di decine di pazienti trattati con questo metodo che ci raccontino di essere guariti? Nell’ultimo anno e mezzo ci sono state poche famiglie che hanno raccontato di benefici, che comunque dovrebbero essere misurati secondo le regole. Non sono prevenuto contro il metodo Stamina: se fosse efficace, sarebbe una benedizione per tutti. Il problema è che l’unico sistema per dimostrarne l’efficacia sarebbe stata una sperimentazione seria, ma non c’è stata».
La decisione del Tar ha risentito della grande pressione mediatica?
«Certamente l’intervento di uomini dello spettacolo, che non conoscono ciò di cui stiamo parlando, ha più risonanza a livello massmediatico di quanta ne ha un ricercatore che lavora in un laboratorio. Alla conclusione dei lavori del Comitato, poi, sarebbe stato opportuno divulgare un’informazione capillare agli uomini di scienza, ai comunicatori e alle famiglie, per far capire che il gruppo di lavoro ha cercato di dare una risposta il più possibile onesta. Mi lascia perplesso che in questo Paese siano i giudici a decidere quello che deve fare la scienza, dimenticando che il codice deontologico stabilisce che un medico non può iniettare sostanze dalla formula dubbia».
E adesso?
«Mi auguro che il Ministero della Salute sappia scegliere un nuovo Comitato capace di mettere la parola fine a questa che è una tipica tragedia italiana. Purtroppo quando non ci sono terapie si creano spazi che sono occupati da persone che promettono quello che la medicina ufficiale non sa promettere. Ma è necessaria sempre una sperimentazione seria per tutelare i pazienti. Perché, se abbiamo una grande invenzione in mano, abbiamo paura a sottoporla a dimostrazione sperimentale?».


